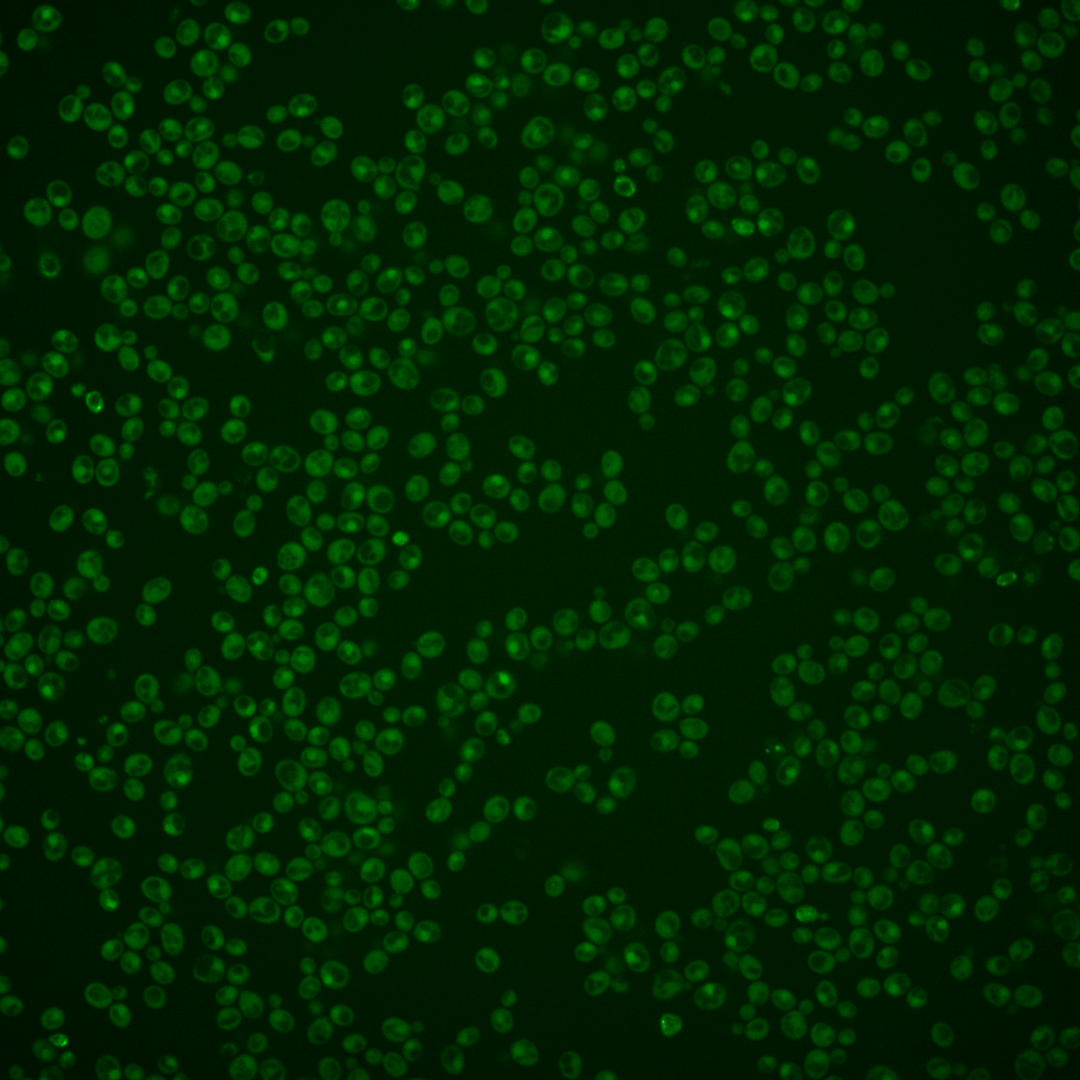
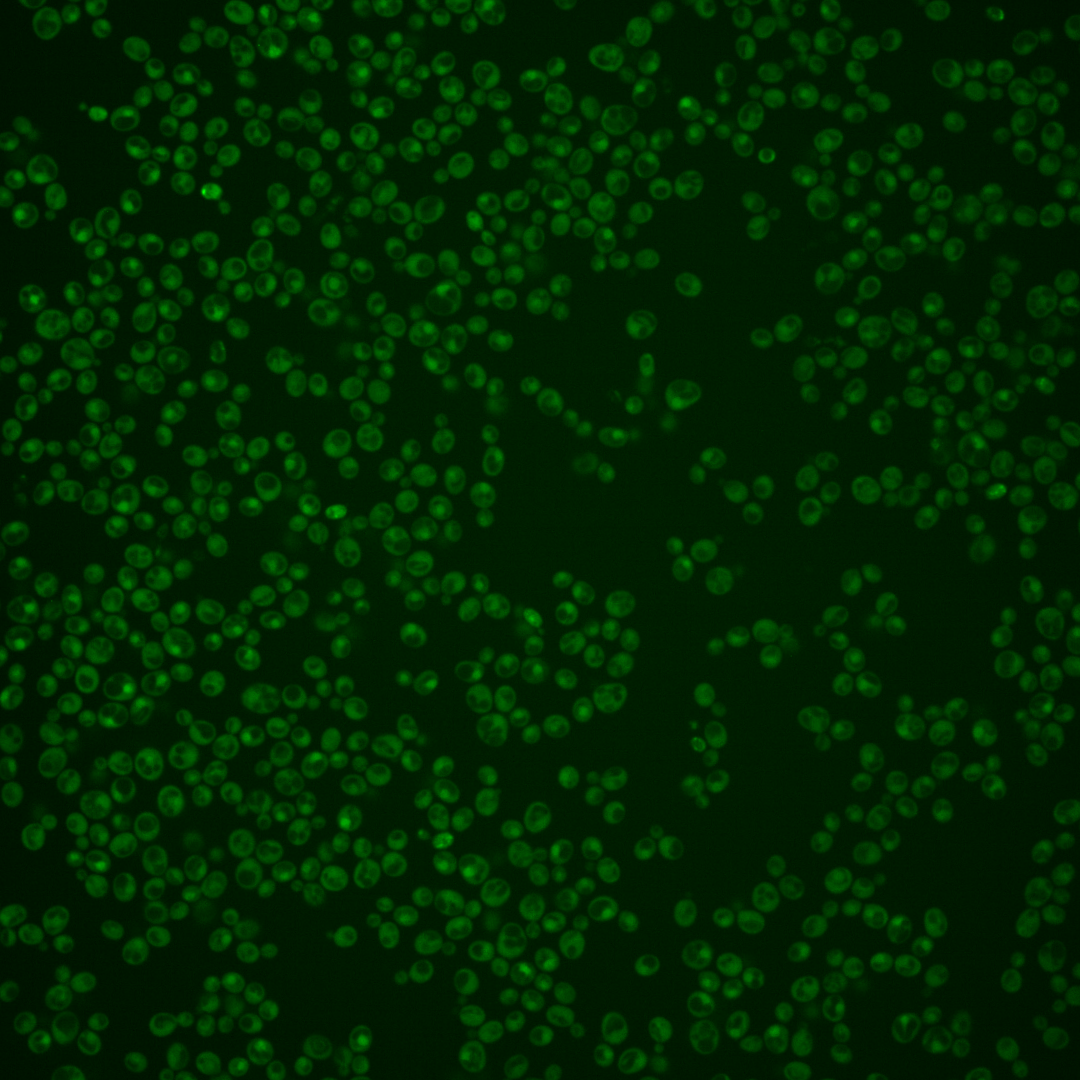
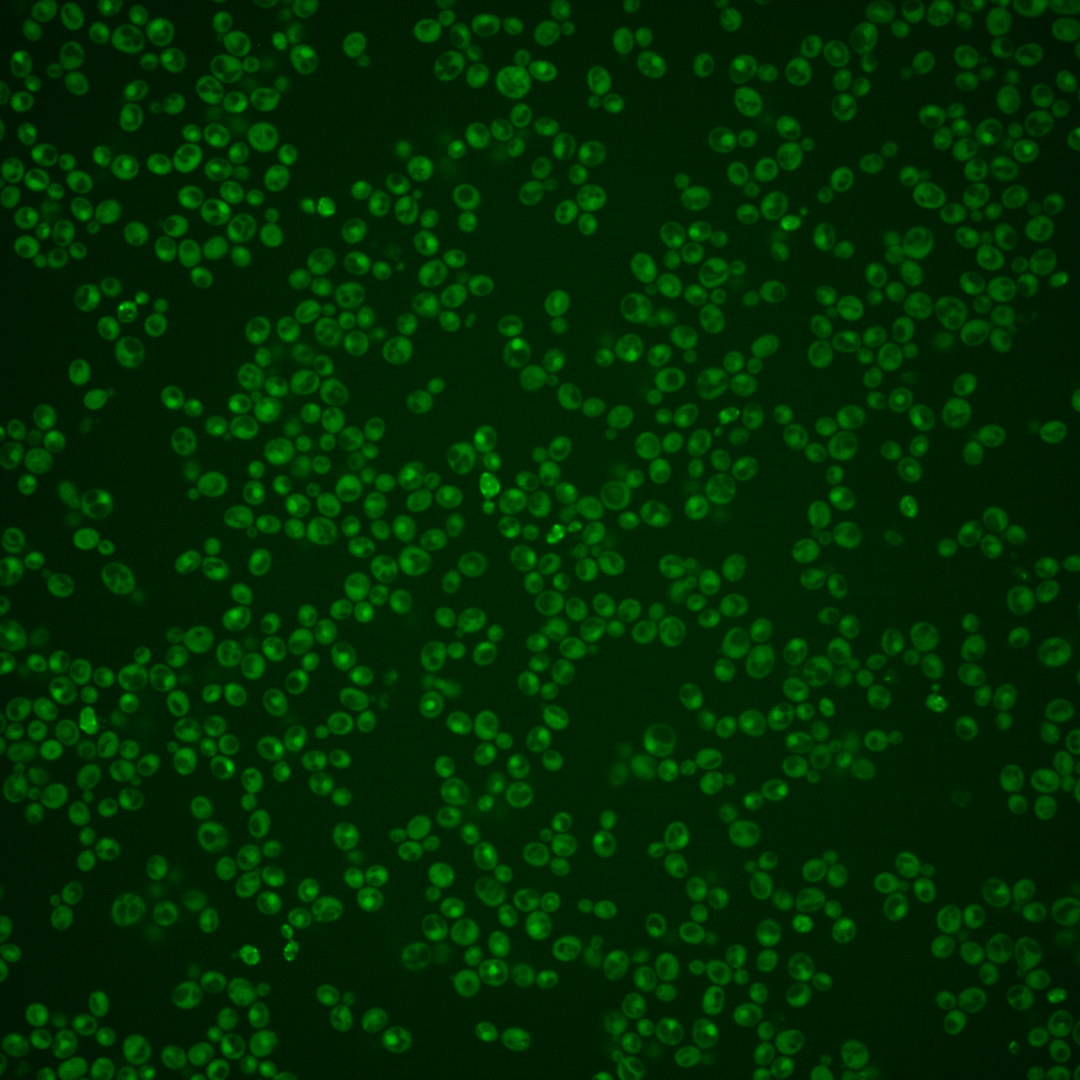
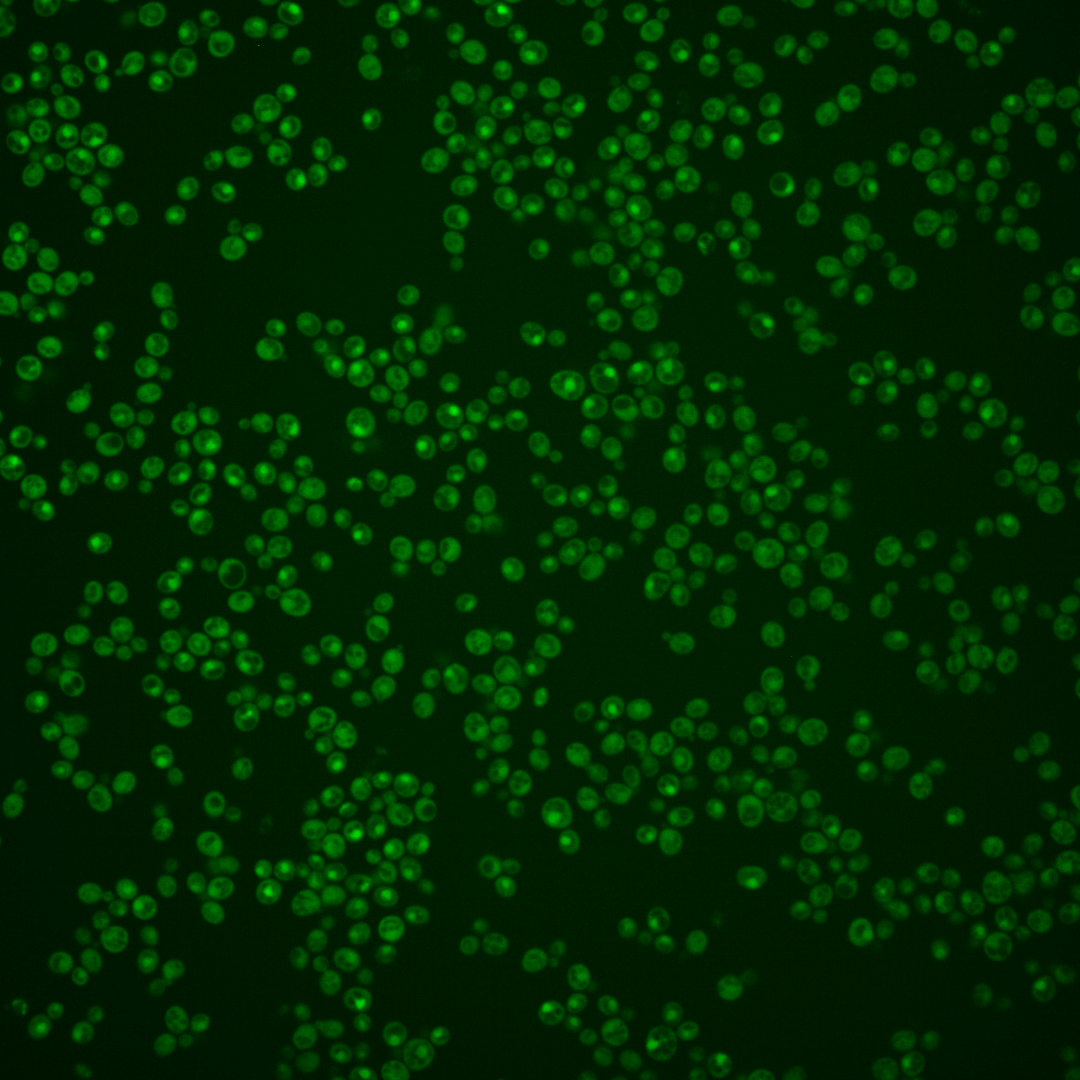
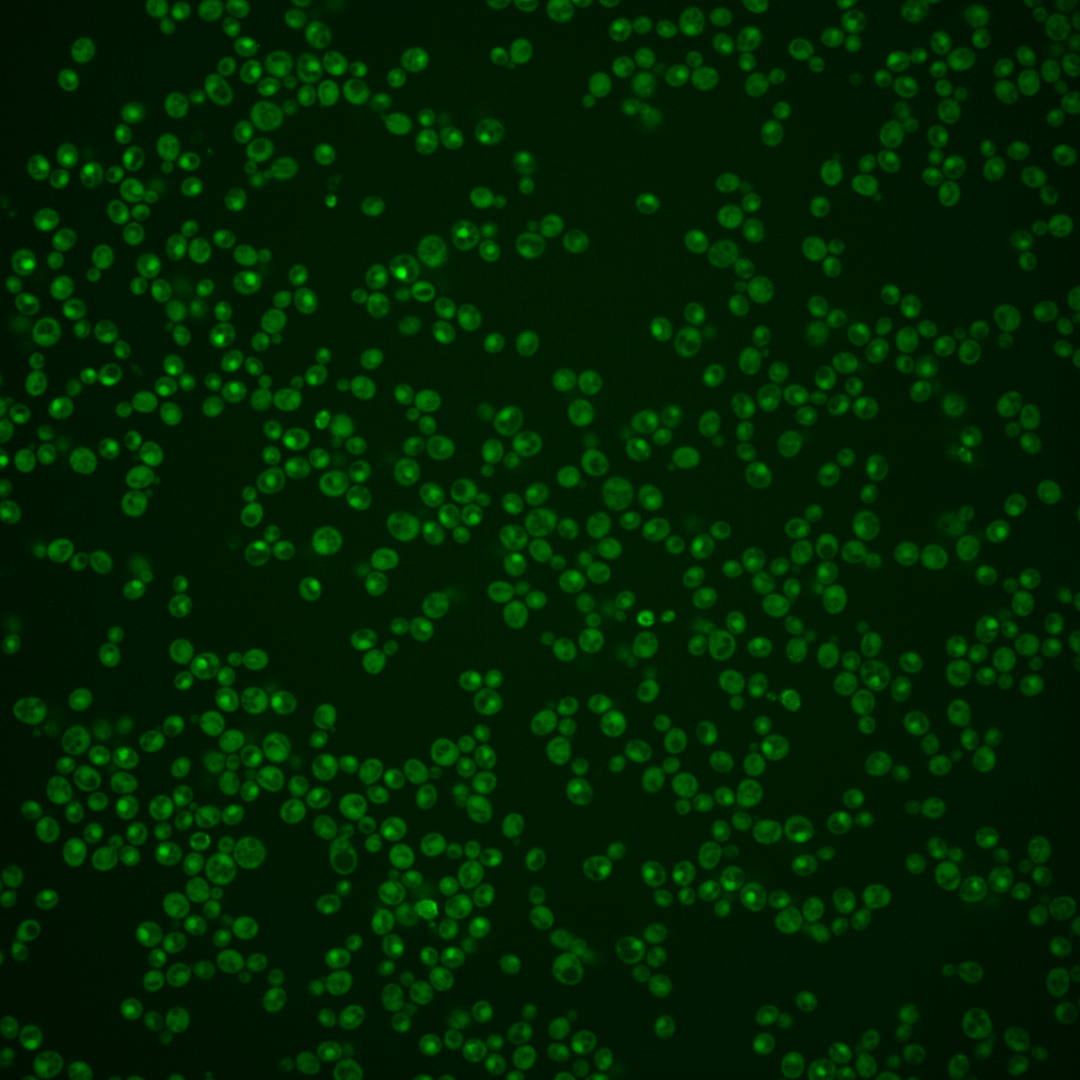

| Standard name | |
|---|---|
| Human Ortholog | |
| Description | DNA replication licensing factor; required for pre-replication complex assembly |
Micrographs




















































































Sub-cellular Localization
Yeast GFP Assignment
Protein Abundance
Localization Change
External localization resources
| ensLOC | DeepLoc | |||||||||||||||||||||||
|---|---|---|---|---|---|---|---|---|---|---|---|---|---|---|---|---|---|---|---|---|---|---|---|---|
| Localization | WT1 | WT2 | WT3 | RAP60 | RAP140 | RAP220 | RAP300 | RAP380 | RAP460 | RAP540 | RAP620 | RAP700 | HU80 | HU120 | HU160 | rpd3Δ_1 | rpd3Δ_2 | rpd3Δ_3 | WT1 | WT2 | WT3 | AF100 | AF140 | AF180 |
| Cortical Patches | 0 | 0 | – | 0 | 0 | 0 | 1 | – | 0 | 0 | 0 | 0 | – | – | – | 1 | 1 | 0 | 0 | 3 | 1 | 0 | 1 | 0 |
| Bud | 0 | 1 | – | 1 | 0 | 2 | 0 | – | 2 | 0 | 0 | 4 | – | – | – | 0 | 0 | 0 | 5 | 9 | 0 | 0 | 1 | 1 |
| Bud Neck | 0 | 0 | – | 0 | 0 | 0 | 0 | – | 0 | 0 | 0 | 0 | – | – | – | 0 | 0 | 0 | 1 | 0 | 0 | 0 | 0 | 0 |
| Bud Site | 0 | 0 | – | 0 | 0 | 0 | 0 | – | 0 | 0 | 1 | 0 | – | – | – | 0 | 0 | 0 | – | – | – | – | – | – |
| Cell Periphery | 0 | 0 | – | 1 | 0 | 0 | 0 | – | 0 | 0 | 1 | 0 | – | – | – | 6 | 12 | 12 | 0 | 0 | 0 | 0 | 0 | 0 |
| Cytoplasm | 124 | 150 | – | 16 | 29 | 96 | 133 | – | 40 | 36 | 54 | 29 | – | – | – | 204 | 198 | 159 | 105 | 131 | 30 | 3 | 6 | 13 |
| Endoplasmic Reticulum | 0 | 4 | – | 0 | 0 | 2 | 2 | – | 0 | 0 | 0 | 0 | – | – | – | 8 | 11 | 10 | 0 | 1 | 0 | 0 | 0 | 0 |
| Endosome | 5 | 1 | – | 1 | 0 | 1 | 1 | – | 0 | 0 | 2 | 1 | – | – | – | 4 | 3 | 5 | 4 | 3 | 0 | 2 | 7 | 1 |
| Golgi | 0 | 2 | – | 0 | 1 | 0 | 0 | – | 0 | 0 | 0 | 0 | – | – | – | 5 | 2 | 2 | 0 | 2 | 0 | 0 | 1 | 0 |
| Mitochondria | 7 | 0 | – | 0 | 0 | 4 | 11 | – | 27 | 24 | 64 | 45 | – | – | – | 6 | 0 | 2 | 1 | 3 | 1 | 0 | 0 | 0 |
| Nucleus | 62 | 65 | – | 1 | 1 | 6 | 7 | – | 7 | 9 | 14 | 8 | – | – | – | 45 | 50 | 31 | 91 | 100 | 7 | 0 | 1 | 3 |
| Nuclear Periphery | 0 | 0 | – | 0 | 0 | 1 | 0 | – | 2 | 0 | 0 | 0 | – | – | – | 0 | 0 | 0 | 0 | 0 | 1 | 0 | 0 | 1 |
| Nucleolus | 0 | 0 | – | 0 | 0 | 0 | 0 | – | 0 | 0 | 0 | 0 | – | – | – | 0 | 0 | 0 | 0 | 1 | 0 | 0 | 1 | 0 |
| Peroxisomes | 0 | 0 | – | 0 | 0 | 0 | 0 | – | 0 | 0 | 0 | 0 | – | – | – | 0 | 0 | 0 | 0 | 0 | 0 | 0 | 0 | 0 |
| SpindlePole | 0 | 0 | – | 0 | 0 | 0 | 0 | – | 0 | 0 | 0 | 0 | – | – | – | 0 | 0 | 0 | 4 | 5 | 0 | 0 | 0 | 0 |
| Vac/Vac Membrane | 58 | 117 | – | 5 | 6 | 7 | 15 | – | 6 | 6 | 4 | 10 | – | – | – | 100 | 92 | 73 | 9 | 26 | 9 | 0 | 3 | 2 |
| Unique Cell Count | 217 | 278 | 22 | 34 | 112 | 163 | 68 | 67 | 109 | 76 | 321 | 323 | 255 | 227 | 294 | 55 | 10 | 28 | 33 | |||||
| Labelled Cell Count | 256 | 340 | 25 | 37 | 119 | 170 | 84 | 75 | 140 | 97 | 379 | 369 | 294 | 227 | 294 | 55 | 10 | 28 | 33 | |||||
Yeast GFP Assignment
Protein Abundance
| Screen | WT1 | WT2 | WT3 | RAP60 | RAP140 | RAP220 | RAP300 | RAP380 | RAP460 | RAP540 | RAP620 | RAP700 | HU80 | HU120 | HU160 | rpd3Δ_1 | rpd3Δ_2 | rpd3Δ_3 | AF100 | AF140 | AF180 |
|---|---|---|---|---|---|---|---|---|---|---|---|---|---|---|---|---|---|---|---|---|---|
| Mean Cell GFP Intensity (1e-4) | 5.6 | 7.7 | – | 7.7 | 7.5 | 6.0 | 6.1 | – | 4.7 | 5.0 | 4.6 | 4.5 | – | – | – | 11.3 | 11.2 | 10.6 | – | – | – |
| Std Deviation (1e-4) | 0.8 | 1.3 | – | 2.4 | 1.7 | 1.4 | 1.9 | – | 0.9 | 1.0 | 2.1 | 1.2 | – | – | – | 1.9 | 2.0 | 1.8 | – | – | – |
| Intensity Change (Log2) | – | – | – | – | – | – | – | – | – | – | – | – | – | – | – | – | – | – | – | – | – |
Localization Change
| Localization | RAP60 | RAP140 | RAP220 | RAP300 | RAP380 | RAP460 | RAP540 | RAP620 | RAP700 | HU80 | HU120 | HU160 | rpd3Δ_1 | rpd3Δ_2 | rpd3Δ_3 |
|---|---|---|---|---|---|---|---|---|---|---|---|---|---|---|---|
| Actin | – | – | – | – | – | – | – | – | – | – | – | – | – | – | – |
| Bud | – | – | – | – | – | – | – | – | – | – | – | – | – | – | – |
| Bud Neck | – | – | – | – | – | – | – | – | – | – | – | – | – | – | – |
| Bud Site | – | – | – | – | – | – | – | – | – | – | – | – | – | – | – |
| Cell Periphery | – | – | – | – | – | – | – | – | – | – | – | – | – | – | – |
| Cyto | – | – | – | – | – | – | – | – | – | – | – | – | – | – | – |
| Endoplasmic Reticulum | – | – | – | – | – | – | – | – | – | – | – | – | – | – | – |
| Endosome | – | – | – | – | – | – | – | – | – | – | – | – | – | – | – |
| Golgi | – | – | – | – | – | – | – | – | – | – | – | – | – | – | – |
| Mitochondria | – | – | – | – | – | – | – | – | – | – | – | – | – | – | – |
| Nuclear Periphery | – | – | – | – | – | – | – | – | – | – | – | – | – | – | – |
| Nuc | – | – | – | – | – | – | – | – | – | – | – | – | – | – | – |
| Nucleolus | – | – | – | – | – | – | – | – | – | – | – | – | – | – | – |
| Peroxisomes | – | – | – | – | – | – | – | – | – | – | – | – | – | – | – |
| SpindlePole | – | – | – | – | – | – | – | – | – | – | – | – | – | – | – |
| Vac | – | – | – | – | – | – | – | – | – | – | – | – | – | – | – |
| Cortical Patches | – | – | – | – | – | – | – | – | – | – | – | – | – | – | – |
| Cytoplasm | – | – | – | – | – | – | – | – | – | – | – | – | – | – | – |
| Nucleus | – | – | – | – | – | – | – | – | – | – | – | – | – | – | – |
| Vacuole | – | – | – | – | – | – | – | – | – | – | – | – | – | – | – |
External localization resources
Images






























Protein Concentration and Protein Localization Data
| R1 | R2 | R3 | ||||||||||||||||
|---|---|---|---|---|---|---|---|---|---|---|---|---|---|---|---|---|---|---|
| G1 Pre-START | G1 Post-START | S/G2 | Metaphase | Anaphase | Telophase | G1 Pre-START | G1 Post-START | S/G2 | Metaphase | Anaphase | Telophase | G1 Pre-START | G1 Post-START | S/G2 | Metaphase | Anaphase | Telophase | |
| Concentration | 1.4094 | 2.0599 | 1.7073 | 1.3226 | 1.8652 | 1.8392 | 1.9923 | 2.5527 | 2.2071 | 2.0984 | 1.972 | 2.1971 | 1.3089 | 2.3416 | 2.005 | 2.1162 | 1.7475 | 1.8968 |
| Actin | 0.0247 | 0.0008 | 0.0028 | 0.0253 | 0.0057 | 0.0008 | 0.0172 | 0.0004 | 0.009 | 0.0141 | 0.013 | 0.0035 | 0.0339 | 0.0015 | 0.0372 | 0.0411 | 0.0097 | 0.006 |
| Bud | 0.001 | 0.0065 | 0.0066 | 0.0124 | 0.0014 | 0.0006 | 0.0007 | 0.0007 | 0.0015 | 0.001 | 0.0005 | 0.0002 | 0.0026 | 0.0069 | 0.0007 | 0.0009 | 0.0031 | 0.0039 |
| Bud Neck | 0.0019 | 0.0008 | 0.0018 | 0.0013 | 0.0011 | 0.0044 | 0.0029 | 0.0009 | 0.0049 | 0.0107 | 0.0019 | 0.0028 | 0.0032 | 0.0005 | 0.0007 | 0.0008 | 0.0015 | 0.0032 |
| Bud Periphery | 0.0018 | 0.0014 | 0.0033 | 0.0038 | 0.0023 | 0.0005 | 0.0009 | 0.0004 | 0.0014 | 0.0008 | 0.0004 | 0.0002 | 0.0023 | 0.0012 | 0.0005 | 0.001 | 0.0015 | 0.0022 |
| Bud Site | 0.0036 | 0.0065 | 0.0036 | 0.0109 | 0.0027 | 0.0004 | 0.0029 | 0.0071 | 0.0065 | 0.0016 | 0.001 | 0.0003 | 0.0103 | 0.0095 | 0.0018 | 0.0018 | 0.0039 | 0.0014 |
| Cell Periphery | 0.0005 | 0.0002 | 0.0002 | 0.0003 | 0.0002 | 0 | 0.0001 | 0.0002 | 0.0003 | 0.0002 | 0.0001 | 0 | 0.0003 | 0.0001 | 0.0001 | 0.0003 | 0.0002 | 0.0002 |
| Cytoplasm | 0.2513 | 0.5183 | 0.6723 | 0.709 | 0.5817 | 0.1505 | 0.1989 | 0.4827 | 0.6328 | 0.6555 | 0.6674 | 0.1425 | 0.2701 | 0.4913 | 0.7451 | 0.5887 | 0.7031 | 0.1823 |
| Cytoplasmic Foci | 0.0146 | 0.0059 | 0.0228 | 0.0126 | 0.0209 | 0.008 | 0.017 | 0.0042 | 0.0162 | 0.0261 | 0.0223 | 0.0044 | 0.0396 | 0.0034 | 0.0123 | 0.0735 | 0.0197 | 0.0057 |
| Eisosomes | 0.0002 | 0 | 0.0001 | 0.0002 | 0.0001 | 0 | 0.0002 | 0 | 0.0001 | 0.0002 | 0.0001 | 0 | 0.0003 | 0 | 0.0001 | 0.0004 | 0.0001 | 0 |
| Endoplasmic Reticulum | 0.0137 | 0.0093 | 0.0095 | 0.0034 | 0.0039 | 0.0022 | 0.0058 | 0.0038 | 0.0052 | 0.0116 | 0.0038 | 0.0017 | 0.0058 | 0.006 | 0.006 | 0.0077 | 0.0019 | 0.002 |
| Endosome | 0.0352 | 0.005 | 0.0341 | 0.0094 | 0.0586 | 0.0142 | 0.0275 | 0.0041 | 0.0116 | 0.0224 | 0.0313 | 0.0057 | 0.0282 | 0.0032 | 0.0195 | 0.0263 | 0.0327 | 0.014 |
| Golgi | 0.0127 | 0.0011 | 0.0059 | 0.004 | 0.0298 | 0.0044 | 0.0031 | 0.0002 | 0.0034 | 0.0057 | 0.0048 | 0.0016 | 0.0108 | 0.0048 | 0.0036 | 0.0267 | 0.0142 | 0.0071 |
| Lipid Particles | 0.0148 | 0.0002 | 0.0114 | 0.0004 | 0.0117 | 0.0021 | 0.0045 | 0.0001 | 0.0048 | 0.008 | 0.0049 | 0.0031 | 0.0071 | 0.0002 | 0.0021 | 0.0335 | 0.0185 | 0.0024 |
| Mitochondria | 0.0139 | 0.0018 | 0.0096 | 0.0213 | 0.0212 | 0.0016 | 0.0041 | 0.0007 | 0.0062 | 0.005 | 0.0019 | 0.0009 | 0.0131 | 0.0008 | 0.0043 | 0.0387 | 0.0104 | 0.0043 |
| None | 0.0767 | 0.0411 | 0.0897 | 0.128 | 0.0527 | 0.0311 | 0.0597 | 0.0511 | 0.1328 | 0.084 | 0.0976 | 0.0156 | 0.0245 | 0.0208 | 0.061 | 0.0799 | 0.056 | 0.0292 |
| Nuclear Periphery | 0.0322 | 0.0193 | 0.0129 | 0.0051 | 0.0038 | 0.0171 | 0.0288 | 0.0115 | 0.0086 | 0.0106 | 0.0156 | 0.0069 | 0.019 | 0.0156 | 0.0092 | 0.0052 | 0.0057 | 0.0079 |
| Nucleolus | 0.0027 | 0.0014 | 0.001 | 0.0026 | 0.0017 | 0.0031 | 0.0047 | 0.0015 | 0.0016 | 0.0012 | 0.001 | 0.003 | 0.0036 | 0.001 | 0.0002 | 0.0003 | 0.0008 | 0.0061 |
| Nucleus | 0.4687 | 0.3621 | 0.0809 | 0.037 | 0.1579 | 0.7312 | 0.5877 | 0.4131 | 0.1239 | 0.1085 | 0.1073 | 0.7874 | 0.4744 | 0.4248 | 0.0816 | 0.0056 | 0.0863 | 0.7083 |
| Peroxisomes | 0.0075 | 0.0002 | 0.0082 | 0.0004 | 0.0222 | 0.0078 | 0.0058 | 0.0002 | 0.0093 | 0.018 | 0.0022 | 0.0025 | 0.0289 | 0.0002 | 0.0039 | 0.0522 | 0.0097 | 0.001 |
| Punctate Nuclear | 0.0117 | 0.0136 | 0.0067 | 0.0057 | 0.0026 | 0.0161 | 0.0211 | 0.013 | 0.0091 | 0.0046 | 0.0179 | 0.0158 | 0.0146 | 0.0053 | 0.0022 | 0.0111 | 0.0144 | 0.0078 |
| Vacuole | 0.0085 | 0.004 | 0.0135 | 0.0059 | 0.0154 | 0.0025 | 0.0048 | 0.0037 | 0.009 | 0.0089 | 0.004 | 0.0014 | 0.0061 | 0.0026 | 0.0043 | 0.003 | 0.0048 | 0.004 |
| Vacuole Periphery | 0.0023 | 0.0006 | 0.003 | 0.0012 | 0.0021 | 0.0013 | 0.0015 | 0.0004 | 0.0016 | 0.0014 | 0.001 | 0.0003 | 0.0014 | 0.0004 | 0.0034 | 0.0013 | 0.0016 | 0.001 |
Sequencing Data
| R1 | R2 | |||||||||
|---|---|---|---|---|---|---|---|---|---|---|
| G1 Post-START | S/G2 | Metaphase | Anaphase | Telophase | G1 Post-START | S/G2 | Metaphase | Anaphase | Telophase | |
| Gene Expression | 37.996 | 47.2808 | 29.4387 | 36.9762 | 30.3463 | 35.8484 | 52.751 | 49.3255 | 43.2674 | 42.3404 |
| Translational Efficiency | 0.4572 | 0.5664 | 0.5265 | 0.4926 | 0.5336 | 0.4865 | 0.4708 | 0.3819 | 0.504 | 0.3532 |
Hit Data
| Dataset | Hit |
|---|---|
| Protein Concentration | ✘ |
| Protein Localization | ✔ |
| Gene Expression | ✔ |
| Translational Efficiency | ✘ |
Endocytosis
| Temp | Actin Patch (Sac6-tdTomato) | Cortical Patch (Sla1-GFP) | Late Endosome (Snf7-GFP) | Vacuole (Vph1-GFP) |
|---|---|---|---|---|
| 37℃ | ||||
| RT |
Cell Cycle Omics
CYCLoPs (Tah11-GFP)
| Gene / Allele | Actin Patch (Sac6-tdTomato) | Cortical Patch (Sla1-GFP) | Late Endosome (Snf7-GFP) | Vacuole (Sac6-tdTomato) |
|---|
| Gene | Images |
|---|
| Gene | Images |
|---|
Images are not yet available
Images are not yet available